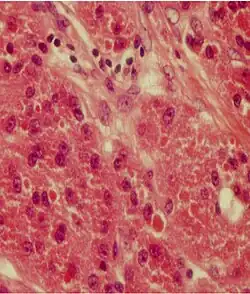

Guz Abrikosowa
| tumor granulocellularis | |
.jpg) | |
| Klasyfikacje | |
| ICD-10 |
D36.1 |
|---|---|
Guz Abrikosowa, guz ziarnistokomórkowy (ang. granular cell myoblastoma, granular cell tumor, granular cell schwannoma, Abrikosoff tumor[1]) – rzadki nowotwór o niejasnej etiologii, być może wywodzący się z osłonek nerwów. Charakterystyczna jest ekspresja genu p53. Występuje najczęściej w 4. i 5. dekadzie życia, częściej u kobiet. Najczęstsza lokalizacja to tkanki miękkie, skóra i śluzówki górnych dróg oddechowych i przewodu pokarmowego; w 40% znajduje się w przedniej części języka, druga najczęstsza lokalizacja to krtań (10%). W 10–25% przypadków guz jest mnogi. Makroskopowo przybiera postać szarego, różowego lub żółtawego guzka średnicy najczęściej do 2 cm. Zwykle występuje pojedynczo. Najczęściej jest zmianą o charakterze łagodnym. Około 2% przypadków może przyjmować postać złośliwą, dając przerzuty do płuc i kości. Leczeniem z wyboru jest całkowita resekcja zmiany. Złośliwe postacie są wrażliwe na radioterapię. Postać łagodna nie jest promienioczuła.
Guz został opisany przez rosyjskiego patologa Aleksieja Abrikosowa[2].

Przypisy
- ↑ Nowotwory w otolaryngologii. Witold Szyfter (red.). Poznań: Termedia, 2012, s. 295. ISBN 978-83-62138-80-7.
- ↑ Abrikossoff AI. Über myome, ausgehend von der quergestreiften willkürlichen Muskulatur. „Virchows Archiv für pathologische Anatomie und Physiologie und für klinische Medizin”. 260, s. 215-33, 1926.
Bibliografia
- Michał Sobjanek, Magdalena Trzeciak, Monika Klimkowska, Adam Włodarkiewicz, Jadwiga Roszkiewicz. Guz ziarnistokomórkowy skóry (guz Abrikosowa) – opis przypadku i przegląd piśmiennictwa. „Post Dermatol Alergol”. 24, 3, s. 140–3, 2007.
- Grażyna Grzesiak-Janas, Wielisław Papierz. Występowanie guza Abrikosowa i włókniaka na języku. „Magazyn stomatologiczny”. 6, 2003.
- Qureshi NA, Tahir M, Carmichael AR. Granular cell tumour of the soft tissues: a case report and literature review. „Int Semin Surg Oncol”. 3, s. 21, 2006-08-24. DOI: 10.1186/1477-7800-3-21. PMID: 16930486. [dostęp 2010-01-05]. (ang.).
- Nowotwory w otolaryngologii. Witold Szyfter (red.). Poznań: Termedia, 2012, s. 295-296. ISBN 978-83-62138-80-7.
Linki zewnętrzne
- Abrikossoff's myoblastoma w bazie Who Named It (ang.)
![]() Przeczytaj ostrzeżenie dotyczące informacji medycznych i pokrewnych zamieszczonych w Wikipedii.
Przeczytaj ostrzeżenie dotyczące informacji medycznych i pokrewnych zamieszczonych w Wikipedii.